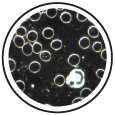
Dunkelfeldmikroskopie

Praxisinfos
Praxis für Innere Medizin, Naturheilverfahren und Homöopathie
© Dr. med. Jürgen Nienhaus
- Impressum
- Datenschutz
Impressum
Dr. med. Jürgen Nienhaus
Arzt für Innere Medizin, Naturheilverfahren,
Homöopathie und Akupunktur
Schloßstraße 14
45468 Mülheim an der Ruhr
Tel.: 0208 - 47 00 22
Fax: 0208 - 47 00 23
Zuständige Ärztekammer: Landesärztekammer Nordrhein
Zuständige Aufsichtsbehörde: Kassenärztliche Vereinigung Nordrhein
Haftungshinweise / Quellenverzeichnis
Haftung für Inhalte
Die Inhalte unserer Seiten wurden mit größter Sorgfalt erstellt. Für die Richtigkeit, Vollständigkeit
und Aktualität der Inhalte können wir jedoch keine Gewähr übernehmen. Als Dienstanbieter sind wir gemäß
§ 7 Abs. 1 TMG für eigene Inhalte auf diesen Seiten nach den allgemeinen Gesetzen verantwortlich. Nach
§§ 8 bis 10 TMG sind wir als Diensteanbieter jedoch nicht verpflichtet, übermittelte oder gespeicherte
fremde Informationen zu überwachen oder nach Umständen zu forschen, die auf eine rechtswidrige Tätigkeit
hinweisen. Verpflichtungen zur Entfernung oder Sperrung der Nutzung von Informationen nach den allgemeinen
Gesetzen bleiben hiervon unberührt. Eine diesbezügliche Haftung ist jedoch erst ab dem Zeitpunkt der Kenntnis
einer konkreten Rechtsverletzung möglich. Bei Bekanntwerden von entsprechenenden Rechtsverletzungen werden wir
diese Inhalte umgehend entfernen.
Haftung für Links
Unser Angebot enthält Links zu externen Webseiten Dritter, auf deren Inhalte wir keinen Einfluss haben.
Deshalb können wir für diese fremden Inhalte auch keine Gewähr übernehmen. Für die Inhalte der verlinkten Seiten
ist stets der jeweilige Anbieter oder Betreiber der Seiten verantwortlich. Die verlinkten Seiten wurden zum Zeitpunkt
der Verlinkung auf mögliche Rechtsverstöße überprüft. Rechtswidrige Inhalte waren zum Zeitpunkt der Verlinkung nicht
erkennbar Eine permanente inhaltliche Kontrolle der verlinkten Seiten ist jedoch ohne konkrete Anhaltspunkte einer
Rechtsverletzung nicht zumutbar. Bei Bekanntwerden von Rechtverletzungen werden wir derartige Links umgehend entfernen.
Urheberrecht
Die durch die Seitenbetreiber erstellten Inhalte und Werke auf diesen Seiten unterliegen dem deutschen Urheberrecht.
Die Vervielfältigung, Bearbeitung, Verbreitung und jede Art der Verwertung außerhalb der Grenzen des Urheberrechtes
bedürfen der schriftlichen Zustimmung des jeweiligen Autors bzw. Erstellers. Downloads und Kopien dieser Seite sind
nur für den privaten, nicht kommerziellen Gebrauch gestattet. Soweit die Inhalte auf dieser Seite nicht vom Betreiber
erstellt wurden, werden die Urheberrechte Dritter beachtet. Insbesondere werden Inhalte Dritter als solche gekennzeichnet.
Sollten Sie trotzdem auf eine Urheberrechtsverletzung aufmerksam werden, bitten wir um einen entsprechenden Hinweis.
Bei Bekanntwerden von Rechtsverletzungen werden wir derartige Inhalte umgehend entfernen.
Der Nutzung von im Rahmen der Impressumspflicht veröffentlichten Kontaktdaten durch Dritte zur Übersendung von nicht
ausdrücklich angeforderter Werbung und Informationsmaterialien wird hiermit ausdrücklich widersprochen. Die Betreiber
der Seiten behalten sich ausdrücklich rechtliche Schritte im Falle der unverlangten Zusendung von Werbeinformationen,
etwa durch Spam-Mails, vor.
Quelle:
Disclaimer von eRecht24, dem Portal zum Internetrecht von Rechtsanwalt Sören Siebert.
fancyBox License:
d946ff81c04e5f8f4d52589de1673863
Fotonachweis Copyright:
(Marina Lohrbach), (Ron Dale) / AdobeStock.com
Webdesign:
Monika Lombardi &
Frank Möhlig GbR
Wallstr. 16
45468 Mülheim a.d. Ruhr
Datenschutz
Unsere Praxis freut sich über Ihren Besuch auf unserer Webseite. Der Schutz Ihrer personenbezogenen Daten bei der Verarbeitung ist für uns ein wichtiges Anliegen und wir möchten, dass Sie sich beim Besuch unserer Internetseiten sicher fühlen. Im Folgenden erläutern wir, welche Informationen unsere Praxis während Ihres Besuches auf unseren Webseiten erfassen und wie diese genutzt werden. Verantwortliche Stelle
Dr. med. Jürgen Nienhaus
Schloßstraße 14
45468 Mülheim an der Ruhr
Tel.: 0208 - 47 00 22
Fax: 0208 - 47 00 23
Personenbezogene Daten
Personenbezogene Daten sind Einzelangaben über persönliche oder sachliche Verhältnisse einer bestimmten oder
bestimmbaren natürlichen Person. Darunter fallen Informationen wie z.B. Ihr richtiger Name, Ihre Anschrift,
Ihre E-Mail Adresse, Unternehmen, Adresse, Telefonnummer und weiteren Informationen über Sie oder Ihr Unternehmen.
Zu persönlichen Informationen können auch Daten zählen, die öffentlich zugänglich sind. Dazu zählen zum Beispiel
Informationen von Sozialen Netzwerken wie z. B. Facebook, LinkedIn, Twitter, Google und weiteren Dienstanbietern.
Erhebung und Verarbeitung von personenbezogenen Daten
Wenn Sie unsere Webseiten besuchen, speichert unser Webserver standardmäßig zum Zweck der Systemsicherheit temporär
die Verbindungsdaten des anfragenden Rechners, die Webseiten, die Sie bei uns besuchen, das Datum und die Dauer des
Besuches, die Erkennungsdaten des verwendeten Browser- und Betriebssystem-Typs sowie die Webseite, von der aus Sie
uns besuchen. Darüber hinausgehende personenbezogene Angaben wie Ihr Name, Ihre Anschrift, Telefonnummer oder E-Mail-
Adresse werden nicht erfasst, es sei denn, diese Angaben werden von Ihnen freiwillig gemacht, z.B. im Rahmen
unserers Service-Formulars.
Kontakt-Formulare
Wenn Sie uns per Kontakt-Formular eine Anfrage zukommen lassen, werden Ihre Angaben aus dem Kontakt-Formular inklusive
der von Ihnen dort angegebenen Daten zwecks Bearbeitung der Anfrage und für den Fall von Anschlussfragen bei uns
gespeichert. Diese Daten geben wir nicht ohne Ihre Einwilligung weiter.
Nach Bearbeitung Ihrer Anfrage, werden diese Daten gelöscht.
Nutzung und Weitergabe der personenbezogenen Daten
Die von Ihnen zur Verfügung gestellten personenbezogenen Daten verwenden wir ausschließlich zum Zweck der Erfüllung Ihrer
Wünsche, also in der Regel zur Abwicklung und zur Beantwortung Ihrer Anfrage. Wir nutzen diese Daten nicht für produktbezogene
Umfragen und Marketingzwecke. Eine Weitergabe, Verkauf oder sonstige Übermittlung Ihrer personenbezogenen Daten an Dritte
erfolgt nicht.
Sicherheit
Unsere Praxis trifft alle notwendigen technischen und organisatorischen Sicherheitsmaßnahmen, um Ihre personenbezogenen Daten
vor Verlust und Missbrauch zu schützen.
So werden Ihre Daten in einer sicheren Betriebsumgebung gespeichert, die der Öffentlichkeit nicht zugänglich ist. Sollten Sie
mit unserer Praxis per E-Mail in Kontakt treten wollen, weisen wir darauf hin, dass die Vertraulichkeit der übermittelten
Informationen nicht gewährleistet ist. Der Inhalt von E-Mails kann von Dritten eingesehen werden. Wir empfehlen Ihnen daher,
uns vertrauliche Informationen ausschließlich über den Postweg zukommen zu lassen.
Betroffenenrechte
Bitte kontaktieren Sie uns jederzeit, wenn Sie sich informieren möchten welche personenbezogenen Daten wir über Sie speichern
bzw. wenn Sie diese berichtigen oder löschen lassen wollen. Desweiteren haben Sie das Recht auf Einschränkung der Verarbeitung
(Art. 18 DSGVO), ein Widerspruchsrechts gegen die Verarbeitung (Art. 21 DSGVO) sowie das Recht auf Datenübertragbarkeit
(Art. 20 DSGVO).
In diesen Fällen wenden Sie sich bitte direkt an uns. Alle Interessenten und Besucher unserer Internetseite erreichen uns in
Datenschutzfragen unter den o.a. Kontaktdaten.
Sollte wir Ihr Anliegen nicht zu Ihrer Zufriedenheit beantworten können, bleibt Ihnen in jedem Falle ihr Recht auf Beschwerde
bei der für Ihr Bundesland zuständigen Datenschutz-Aufsichtsbehörde.